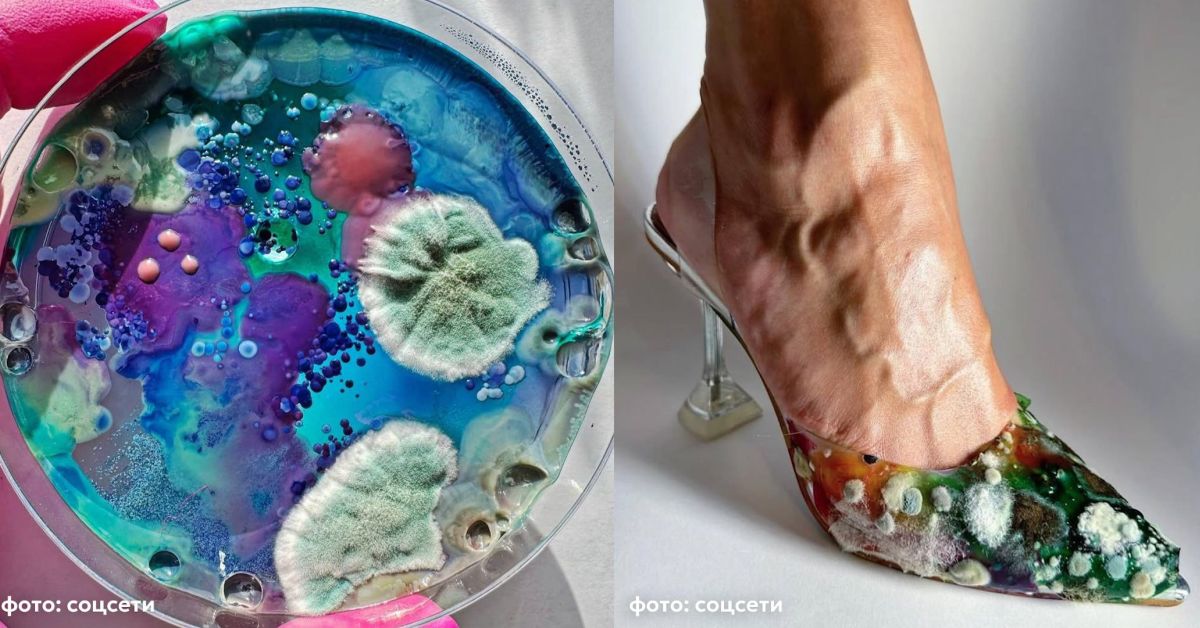
Новый писк женской моды в РФ: боевая раскраска собственной плесенью

Еще один способ сделать свое тело источником творческого вдохновения. Это ж надо было додуматься!..

Кстати, об извратах:
А про маникюр со спермой вы слышали?
Еще один способ сделать свое тело источником творческого вдохновения. Это ж надо было додуматься!..
А про маникюр со спермой вы слышали?